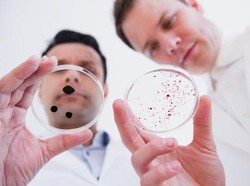
Apa Saja Bagian Struktur Bakteri dan Fungsinya? Yuk Kenali!

detikEdu
Apa Saja Bagian Struktur Bakteri dan Fungsinya? Yuk Kenali!
Struktur bakteri terdiri atas dinding sel dan membran plasma. Namun selain itu ada penyusun lainnya. Apa saja? Berikut penjelasan dan fungsinya!
Minggu, 31 Mar 2024 07:00 WIB